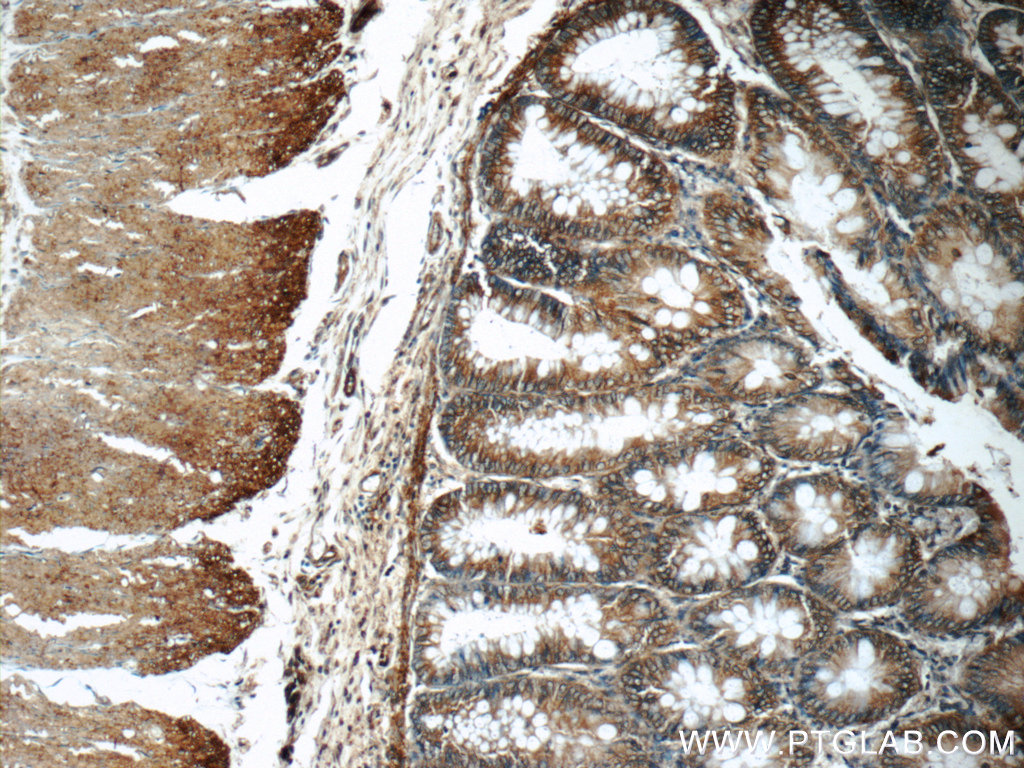
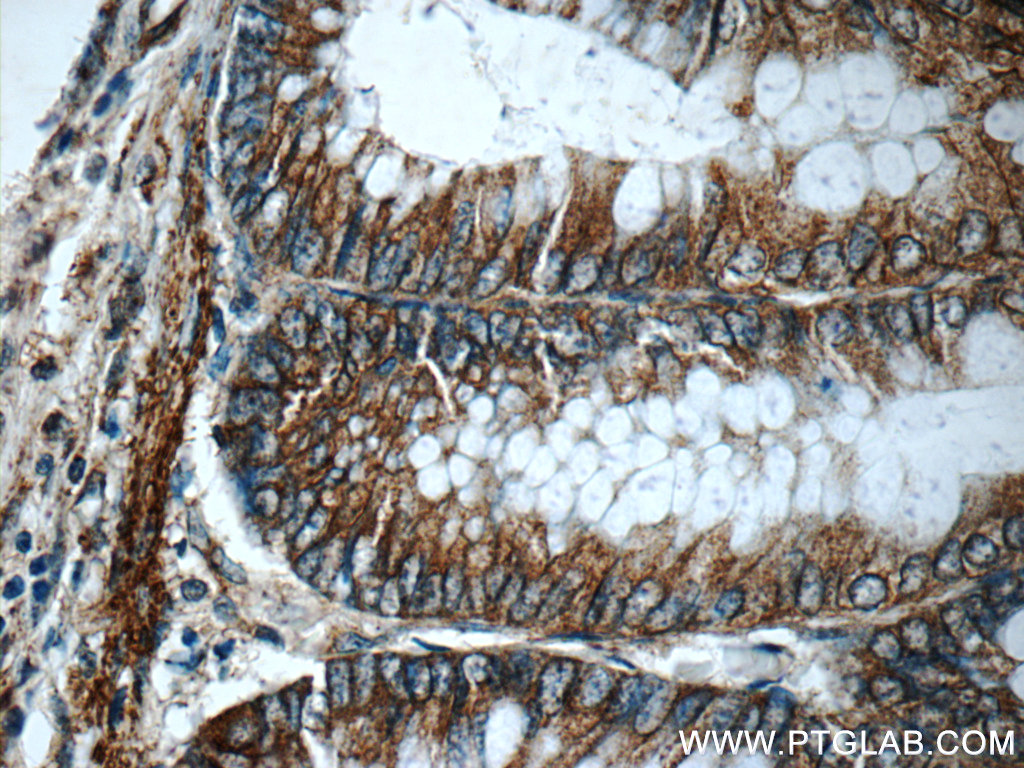

验证数据展示
经过测试的应用
| Positive WB detected in | mouse uterus tissue |
| Positive IP detected in | mouse brain tissue |
| Positive IHC detected in | human colon tissue, human pancreas cancer tissue Note: suggested antigen retrieval with TE buffer pH 9.0; (*) Alternatively, antigen retrieval may be performed with citrate buffer pH 6.0 |
| Positive IF/ICC detected in | A431 cells |
推荐稀释比
| 应用 | 推荐稀释比 |
|---|---|
| Western Blot (WB) | WB : 1:1000-1:4000 |
| Immunoprecipitation (IP) | IP : 0.5-4.0 ug for 1.0-3.0 mg of total protein lysate |
| Immunohistochemistry (IHC) | IHC : 1:600-1:2400 |
| Immunofluorescence (IF)/ICC | IF/ICC : 1:10-1:100 |
| It is recommended that this reagent should be titrated in each testing system to obtain optimal results. | |
| Sample-dependent, Check data in validation data gallery. | |
产品信息
12831-1-AP targets Alpha E-Catenin in WB, IHC, IF/ICC, IP, ELISA applications and shows reactivity with human, mouse, rat samples.
| 经测试应用 | WB, IHC, IF/ICC, IP, ELISA Application Description |
| 文献引用应用 | WB, IF |
| 经测试反应性 | human, mouse, rat |
| 文献引用反应性 | human, mouse, rat |
| 免疫原 |
CatNo: Ag3565 Product name: Recombinant human CTNNA1 protein Source: e coli.-derived, PGEX-4T Tag: GST Domain: 188-536 aa of BC031262 Sequence: SEMDNYEPGVYTEKVLEATKLLSNTVMPRFTEQVEAAVEALSSDPAQPMDENEFIDASRLVYDGIRDIRKAVLMIRTPEELDDSDFETEDFDVRSRTSVQTEDDQLIAGQSARAIMAQLPQEQKAKIAEQVASFQEEKSKLDAEVSKWDDSGNDIIVLAKQMCMIMMEMTDFTRGKGPLKNTSDVISAAKKIAEAGSRMDKLGRTIADHCPDSACKQDLLAYLQRIALYCHQLNICSKVKAEVQNLGGELVVSGVDSAMSLIQAAKNLMNAVVQTVKASYVASTKYQKSQGMASLNLPAVSWKMKAPEKKPLVKREKQDETQTKIKRASQKKHVNPVQALSEFKAMDSI 种属同源性预测 |
| 宿主/亚型 | Rabbit / IgG |
| 抗体类别 | Polyclonal |
| 产品类型 | Antibody |
| 全称 | catenin (cadherin-associated protein), alpha 1, 102kDa |
| 别名 | CTNNA1, alpha catenin, Alpha E catenin, CAP102, Catenin alpha 1 |
| 计算分子量 | 906 aa, 100 kDa |
| 观测分子量 | 100 kDa |
| GenBank蛋白编号 | BC031262 |
| 基因名称 | Alpha E-Catenin |
| Gene ID (NCBI) | 1495 |
| RRID | AB_2087822 |
| 偶联类型 | Unconjugated |
| 形式 | Liquid |
| 纯化方式 | Antigen affinity purification |
| UNIPROT ID | P35221 |
| 储存缓冲液 | PBS with 0.02% sodium azide and 50% glycerol, pH 7.3. |
| 储存条件 | Store at -20°C. Stable for one year after shipment. Aliquoting is unnecessary for -20oC storage. |
背景介绍
Alpha catenin is an essential component of adherens junctions that connects E-cadherin-β-catenin complexes with the actin cytoskeleton. It also recruits a range of other important proteins to developing intercellular junctions. Three alpha catenins exist in human: alpha-E-catenin, alpha-N-catenin, and alpha-T-catenin, which share substantial amino-acid sequence similarity but have distinct tissue distribution. alpha-E-catenin is ubiquitously expressed, alpha-N-catenin is restricted to neuronal tissue, and alpha-T-catenin is primarily expressed in heart tissue. Reduced levels of alpha-E-catenin protein seem to be characteristic of many different human cancers, including malignant tumours of the breast, colon, stomach, oesophagus, bladder and liver. In addition, the loss of alpha-E-catenin often correlates with the degree of tumour differentiation and metastasis.
实验方案
| Product Specific Protocols | |
|---|---|
| IF protocol for Alpha E-Catenin antibody 12831-1-AP | Download protocol |
| IHC protocol for Alpha E-Catenin antibody 12831-1-AP | Download protocol |
| IP protocol for Alpha E-Catenin antibody 12831-1-AP | Download protocol |
| WB protocol for Alpha E-Catenin antibody 12831-1-AP | Download protocol |
| Standard Protocols | |
|---|---|
| Click here to view our Standard Protocols |
发表文章
| Species | Application | Title |
|---|---|---|
Oncogene Transducin (β)-like 1 X-linked receptor 1 promotes gastric cancer progression via the ERK1/2 pathway. | ||
Elife Selective YAP activation in Procr cells is essential for ovarian stem/progenitor expansion and epithelium repair. | ||
Oncogene The reciprocal interaction between tumor cells and activated fibroblasts mediated by TNF-α/IL-33/ST2L signaling promotes gastric cancer metastasis. | ||
Helicobacter Helicobacter pylori Dwelling on the Apical Surface of Gastrointestinal Epithelium Damages the Mucosal Barrier Through Direct Contact. | ||
Cells P-Cadherin Regulates Intestinal Epithelial Cell Migration and Mucosal Repair, but Is Dispensable for Colitis Associated Colon Cancer. | ||
Sci Rep SPOCK1 is a novel inducer of epithelial to mesenchymal transition in drug-induced gingival overgrowth. |